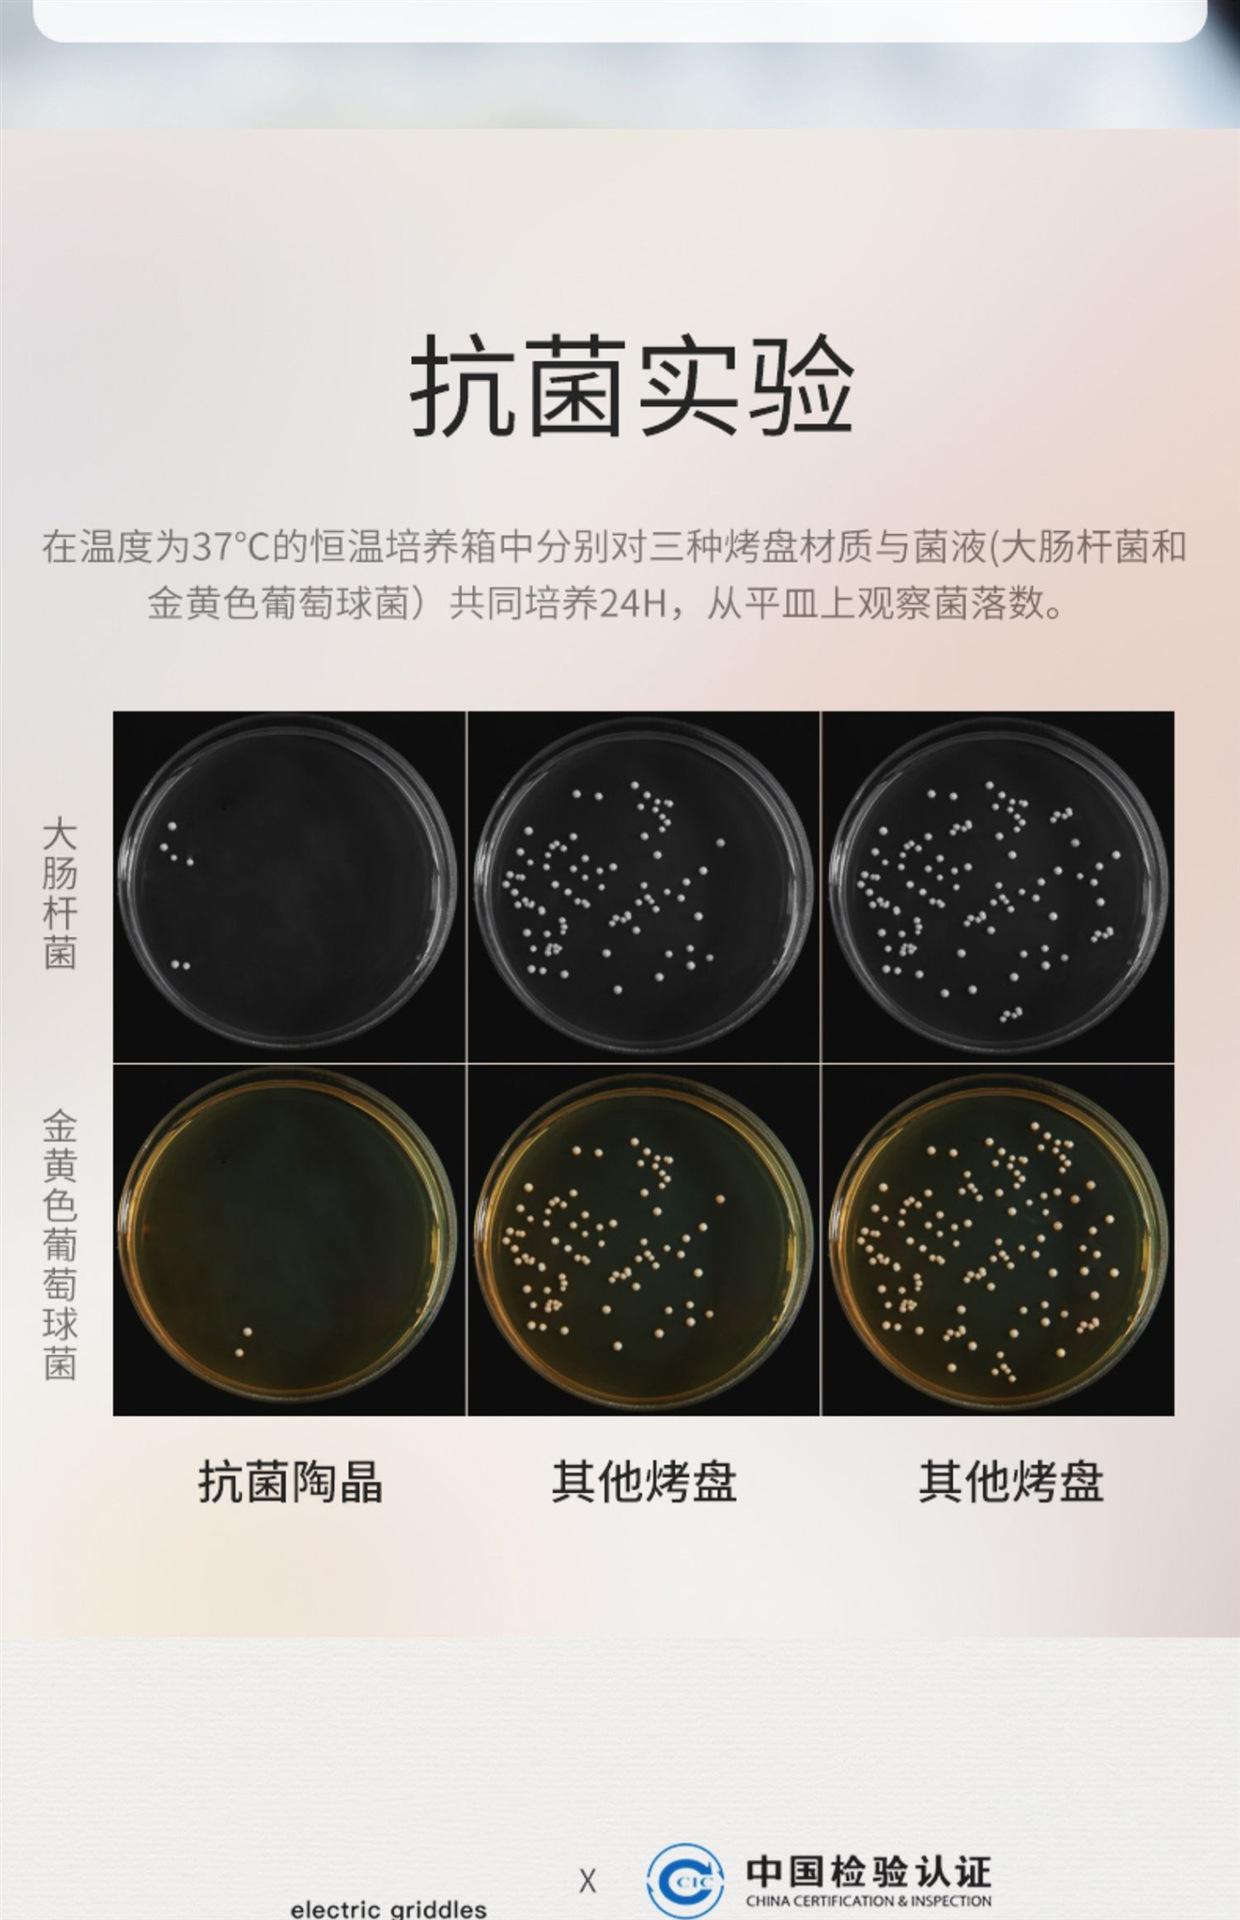

O texto nas imagens pode ser traduzido
Churrasqueira elétrica doméstica sem fumaça Placa de grelha elétrica antiaderente de estilo coreano Panela de churrasco interna Placa de ferro Máquina de grelhar peixe grelhado
Certificação necessária
Preço por unidade incluindo frete para o Brasil
Variantes

[black ordinary style-extra large] + 5-piece set
De 161 un

Black regular model-extra large size
De 161 un

[black ordinary style-extra large] + 9-piece set
De 161 un
Especificações do produto
Marca
Other
Processo da parte principal
Electrophoresis
Peso
Other
Especificações da grelha/panela
White upgraded medical stone-large size, [white upgraded medical stone-large size] + 5-piece set, [white upgra...
Número aplicável
More than 5 people
Origem
Other
estilo
Korean style
Existe uma patente?
No
Função
Fold
Marca
Other
Processo da parte principal
Electrophoresis
Peso
Other
Especificações da grelha/panela
White upgraded medical stone-large size, [white upgraded medical stone-large size] + 5-piece set, [white upgra...
Número aplicável
More than 5 people
Origem
Other
estilo
Korean style
Existe uma patente?
No
Função
Fold
Marca
Other
Processo da parte principal
Electrophoresis
Peso
Other
Especificações da grelha/panela
White upgraded medical stone-large size, [white upgraded medical stone-large size] + 5-piece set, [white upgra...
Número aplicável
More than 5 people
Origem
Other
estilo
Korean style
Existe uma patente?
No
Função
Fold
Detalhes do produto
O texto nas imagens pode ser traduzido

Total
Entrega
ICMS
PIS e COFINS
Outro









